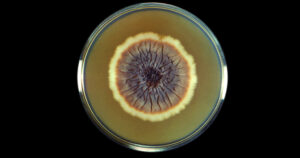

Quando o lucro cala direitos, é hora de regular
Publicado originalmente em Le Monde Diplomatique Brasil O Le Monde Diplomatique Brasil publicou um artigo abordando o modelo de negócios das plataformas digitais, a violação

Publicado originalmente em Le Monde Diplomatique Brasil O Le Monde Diplomatique Brasil publicou um artigo abordando o modelo de negócios das plataformas digitais, a violação

Publicado originalmente no site do Ministério da Ciência, Tecnologia e Inovação Foi publicada nesta semana a versão final do Plano Brasileiro de Inteligência Artificial (PBIA),

Publicado originalmente em Agência Bori. Acesse na íntegra aqui. A estabilidade das relações pode influenciar mais o uso de camisinha por homens cis (designados como

Publicado originalmente em *Desinformante por Glenda Dantas. Acesse na íntegra aqui. “Você merece viver a sua melhor versão.”“Seu corpo tem o poder de se curar
Publicado originalmente em Jornal da USP. Acesse na íntegra aqui. A esporotricose é a micose subcutânea mais prevalente no mundo, sobretudo em áreas tropicais e

Publicado originalmente em Coletivo Bereia por Maria Eduarda Goulart e Viviane Castanheira. Acesse na íntegra aqui. Um vídeo com críticas ao deputado federal Nikolas Ferreira

Publicado originalmente em Agência Lupa por Maiquel Rosauro. Acesse na íntegra aqui. Post nas redes sociais traz um vídeo com o jogador de futebol Giorgian